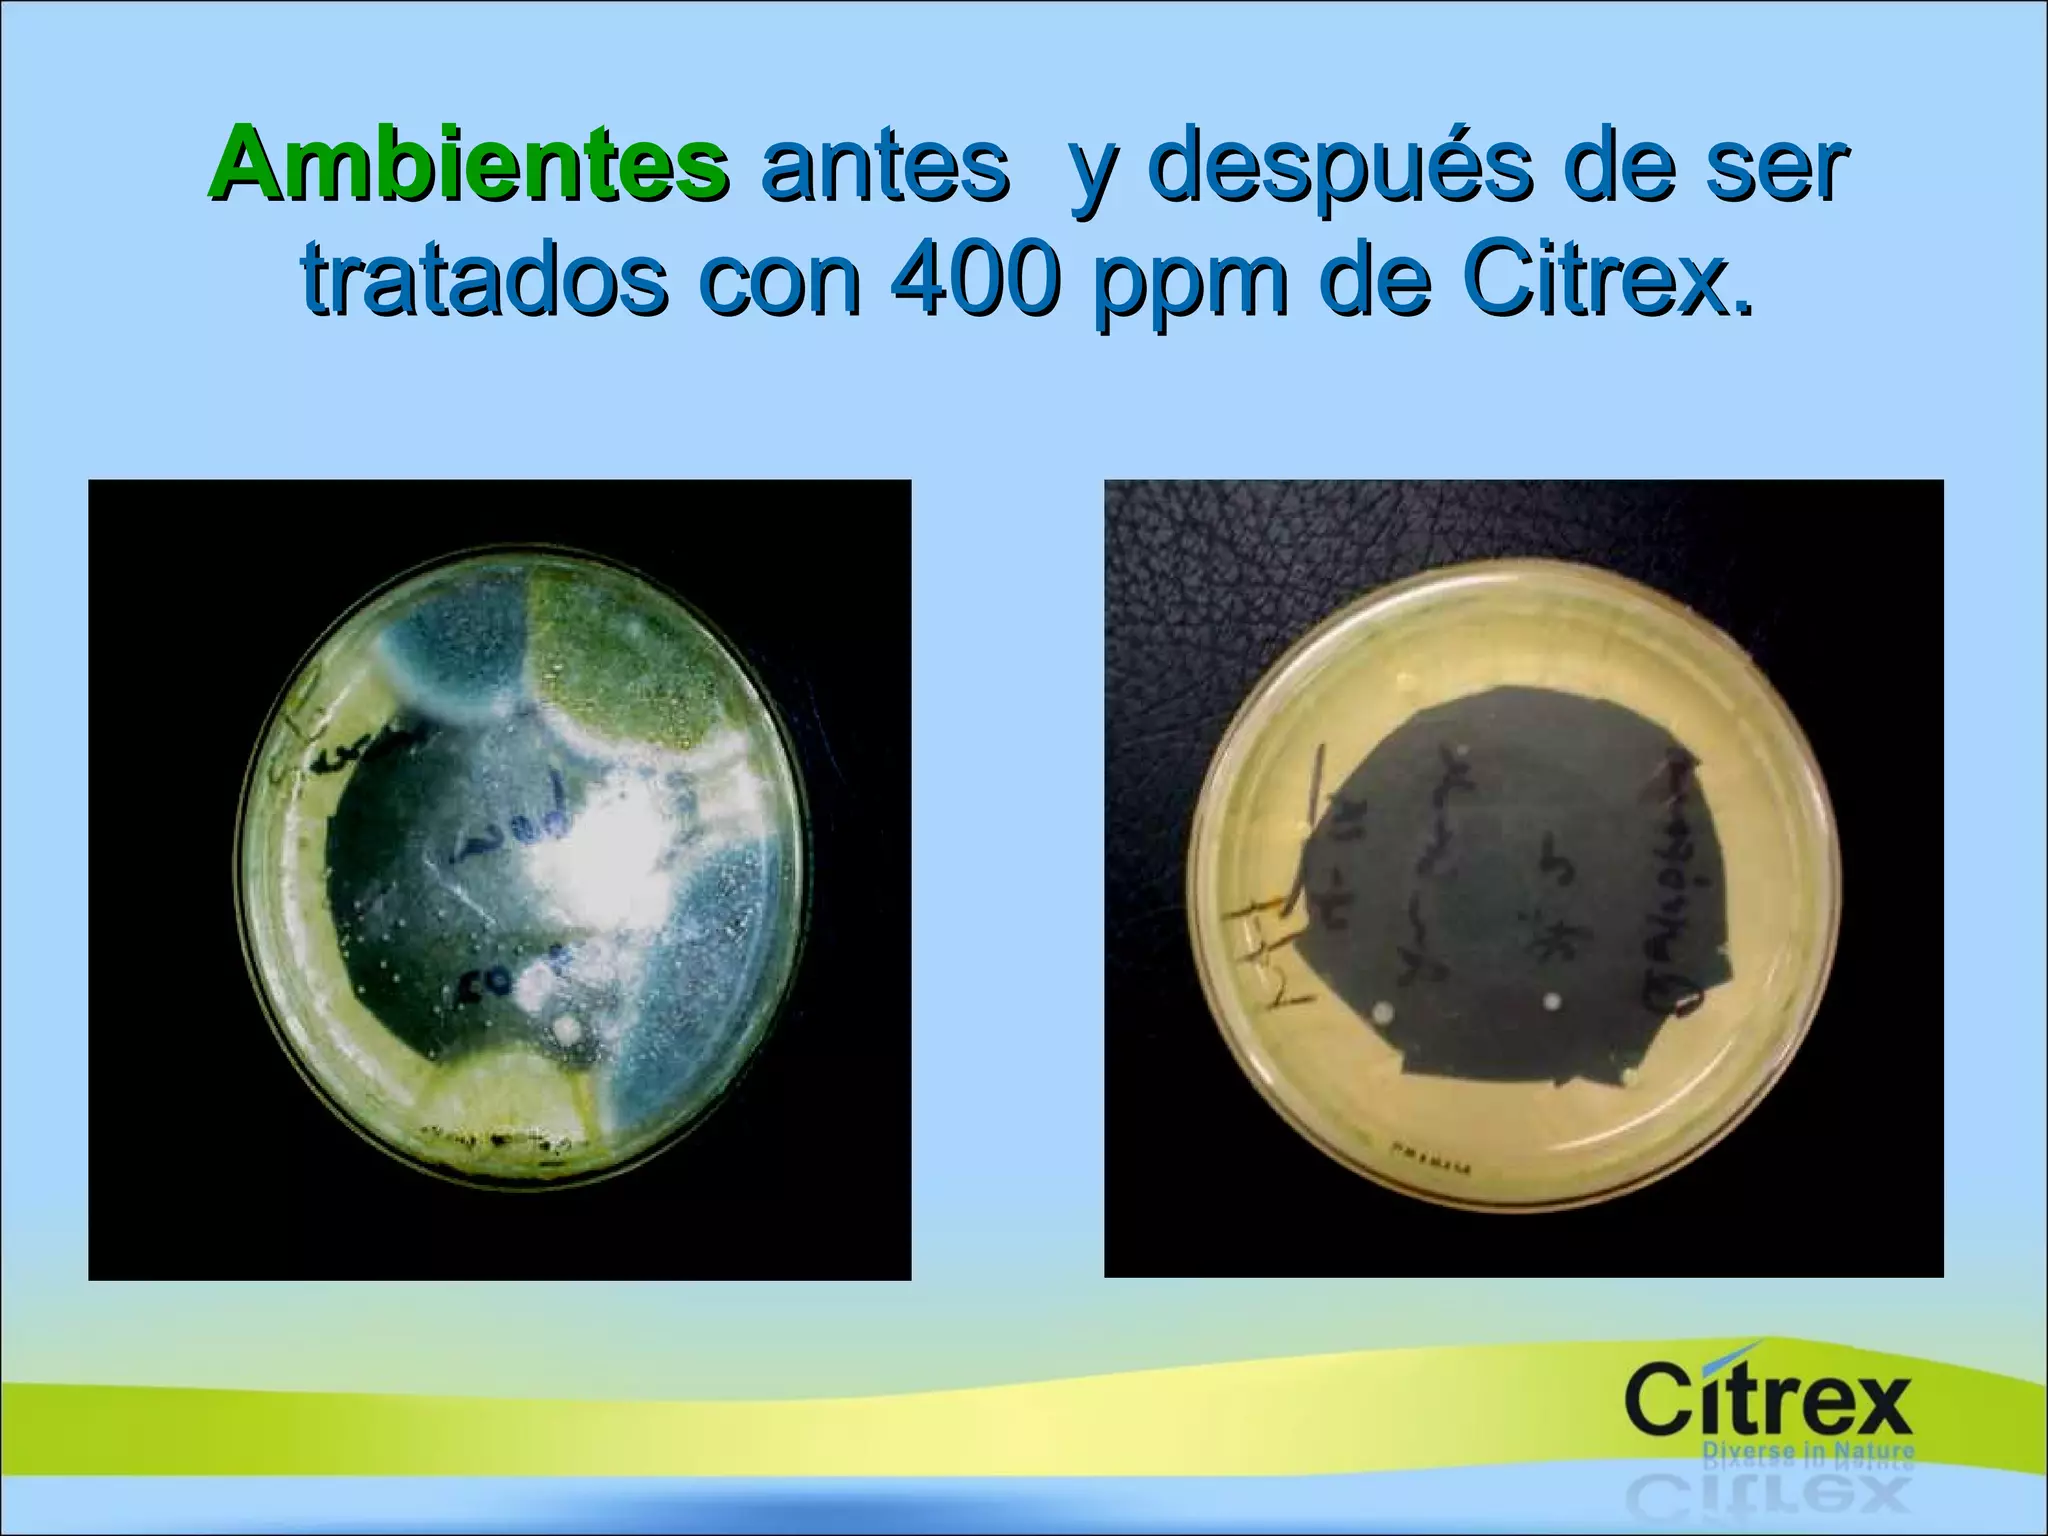
Ambientes  antes  y después de ser tratados con 400 ppm de Citrex.

El documento evalúa la actividad inhibitoria y microbicida de la molécula Citrex en superficies de contacto directo con alimentos y en ambientes de salas de producción. Se aplicó Citrex a 200 y 400 ppm en superficies y se nebulizó a 400 ppm en ambientes. Esto redujo significativamente la carga microbiana en superficies y disminuyó los mohos y levaduras en ambientes en comparación con antes del tratamiento.